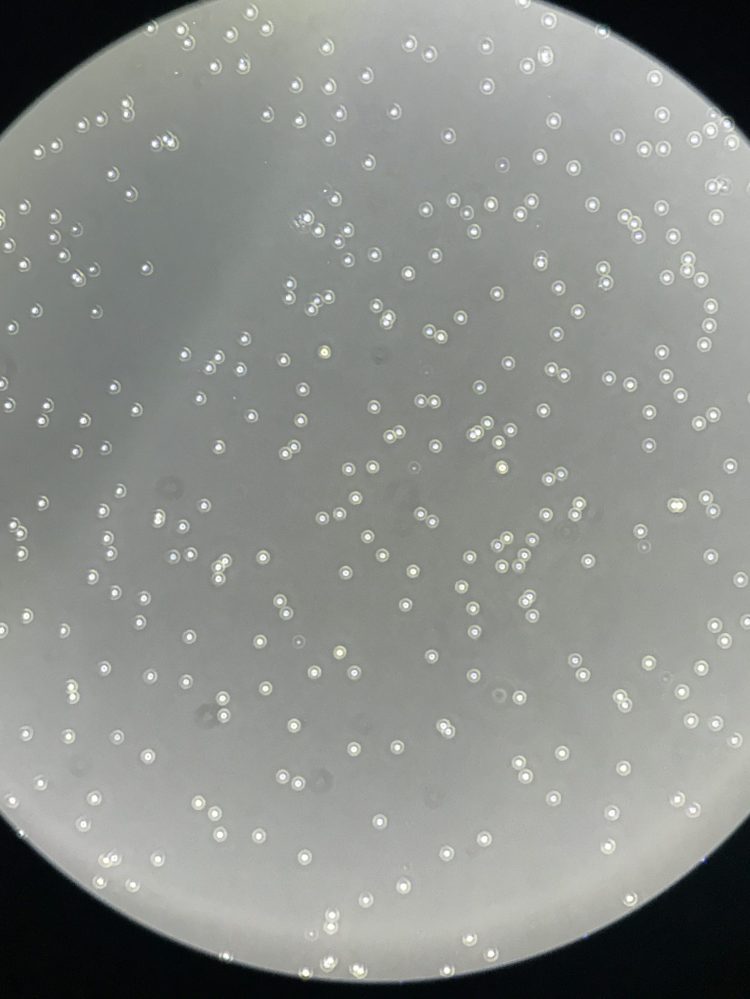

Pawlowic Lab Values: Honesty, Collaborativeness, Trustworthiness, Dedication, Enthusiasm
PI, Sir Henry Dale Fellow
Mattie Christie Pawlowic
Postdoc, Striepen Lab
PhD, Biology from Texas Tech University
BS, Cell and Molecular Biology from Texas Tech University
Editor, mSphere

In Vivo Scientist
Lee Robinson
Previous experience at Huntingdon Life Sciences, Envigo, and the Wellcome Sanger Institute.

PhD Candidate (BBSRC, EastBio)
Peyton Goddard
Integrated Masters, Genetics, University of Sheffield

PhD Candidate (BBSRC, EastBio)
Sarah Stevens
Integrated Masters, Biology/Biological Sciences, University of York
Summer Research Student, Faria Lab, University of York

Coming soon…
Postdoctoral Researcher
Douglas Escrivani
PhD, Biological Sci and Biological Chemistry from Durham University (UK) & Federal University of Rio de Janeiro (Brazil)
MSc, Bio Sci from Federal University of Rio de Janeiro
BSc, Pharmacy/Biochem from Federal University of Rio de Janeiro

Postdoctoral Researcher
Sophia Hernandez
PhD, Molecular Biology from Umeå University
BSc, Molecular Biology and Biotechnology from University of the Philippines Diliman

Postdoctoral Researcher,
joint with Mode of Action Team with Prof. Susan Wyllie
Sandra Carvalho
PhD, University of Porto

Lab Alumni

Left:
Middle: Finlay Walker, Honours Student (Autumn 2025)
Right: Dr. Grant MJ Hall, MRC funded PhD student (viva Nov 2025)



Left: Sam Ferguson, Wellcome funded summer vacation scholarship student; currently Honours Student Ciulli Lab
Middle: Kai Lynn Wong, MRes Student (Jan – Oct 2024); PhD student Penn State starting Sept 2025!
Right: Beth Dow, Honours Student (Fall 2023); Senior Biology Technician at Strathallan School, Perthshire



Left: Dr. Simona Seizova, Postdoctoral Researcher joint with Mode-of-Action group (2021-2023); currently postdoc at WEHI
Middle: Emma Carrington, Wellcome funded summer vacation scholarship student; currently Biotechnology MSci at QMUL
Right: Flora Caldwell, Honours Student (Autumn 2021), Research Laboratory Technician (Summer 2022), Integrated Masters Projects (2022-2023); currently EASTBio PhD student in Young Lab, in collaboration with Nisha Philip and Joanne Thompson



Left: Dr. Ross Bacchetti, WCAIR funded PhD student (viva Sept 2022); currently Clinical Scientist in Microbiology, Scottish Microbiology Reference Lab, NHS Greater Glasgow and Clyde
Middle: Dr. Emma Robson (previously Emma Sands), Wellcome Trust funded PhD student (viva Dec 2022); currently Service Planner- Flooding at Scottish Water
Right: Dr. Jack Hanna, MRC funded PhD student (viva Jan 2023); currently postdoctoral researcher in Dr. Clare Harding’s lab in Glasgow



Left: Dr. Beatrice Colon, Postdoctoral Researcher (2018-2023); currently North England Account Manager in Life Sciences at Promega
Middle: Sophie Rappich, Wellcome Trust Rotation student (Spring 2022); currently PhD student in Greg Findlay’s lab at Dundee
Right: Dr. Nina Svensen, Postdoctoral Researcher in the DDU; currently independent consulting for medical and scientific writing



Left: Senyo Botchie, WCAIR Trainee (2019-2020)
Middle: Stephen Andrews, Honours Student (Fall 2019); currently MRC PhD student in Arthur lab at Dundee
Right: Peter Stratton, Honours Science Communication Student (Fall 2020); check out his project HERE